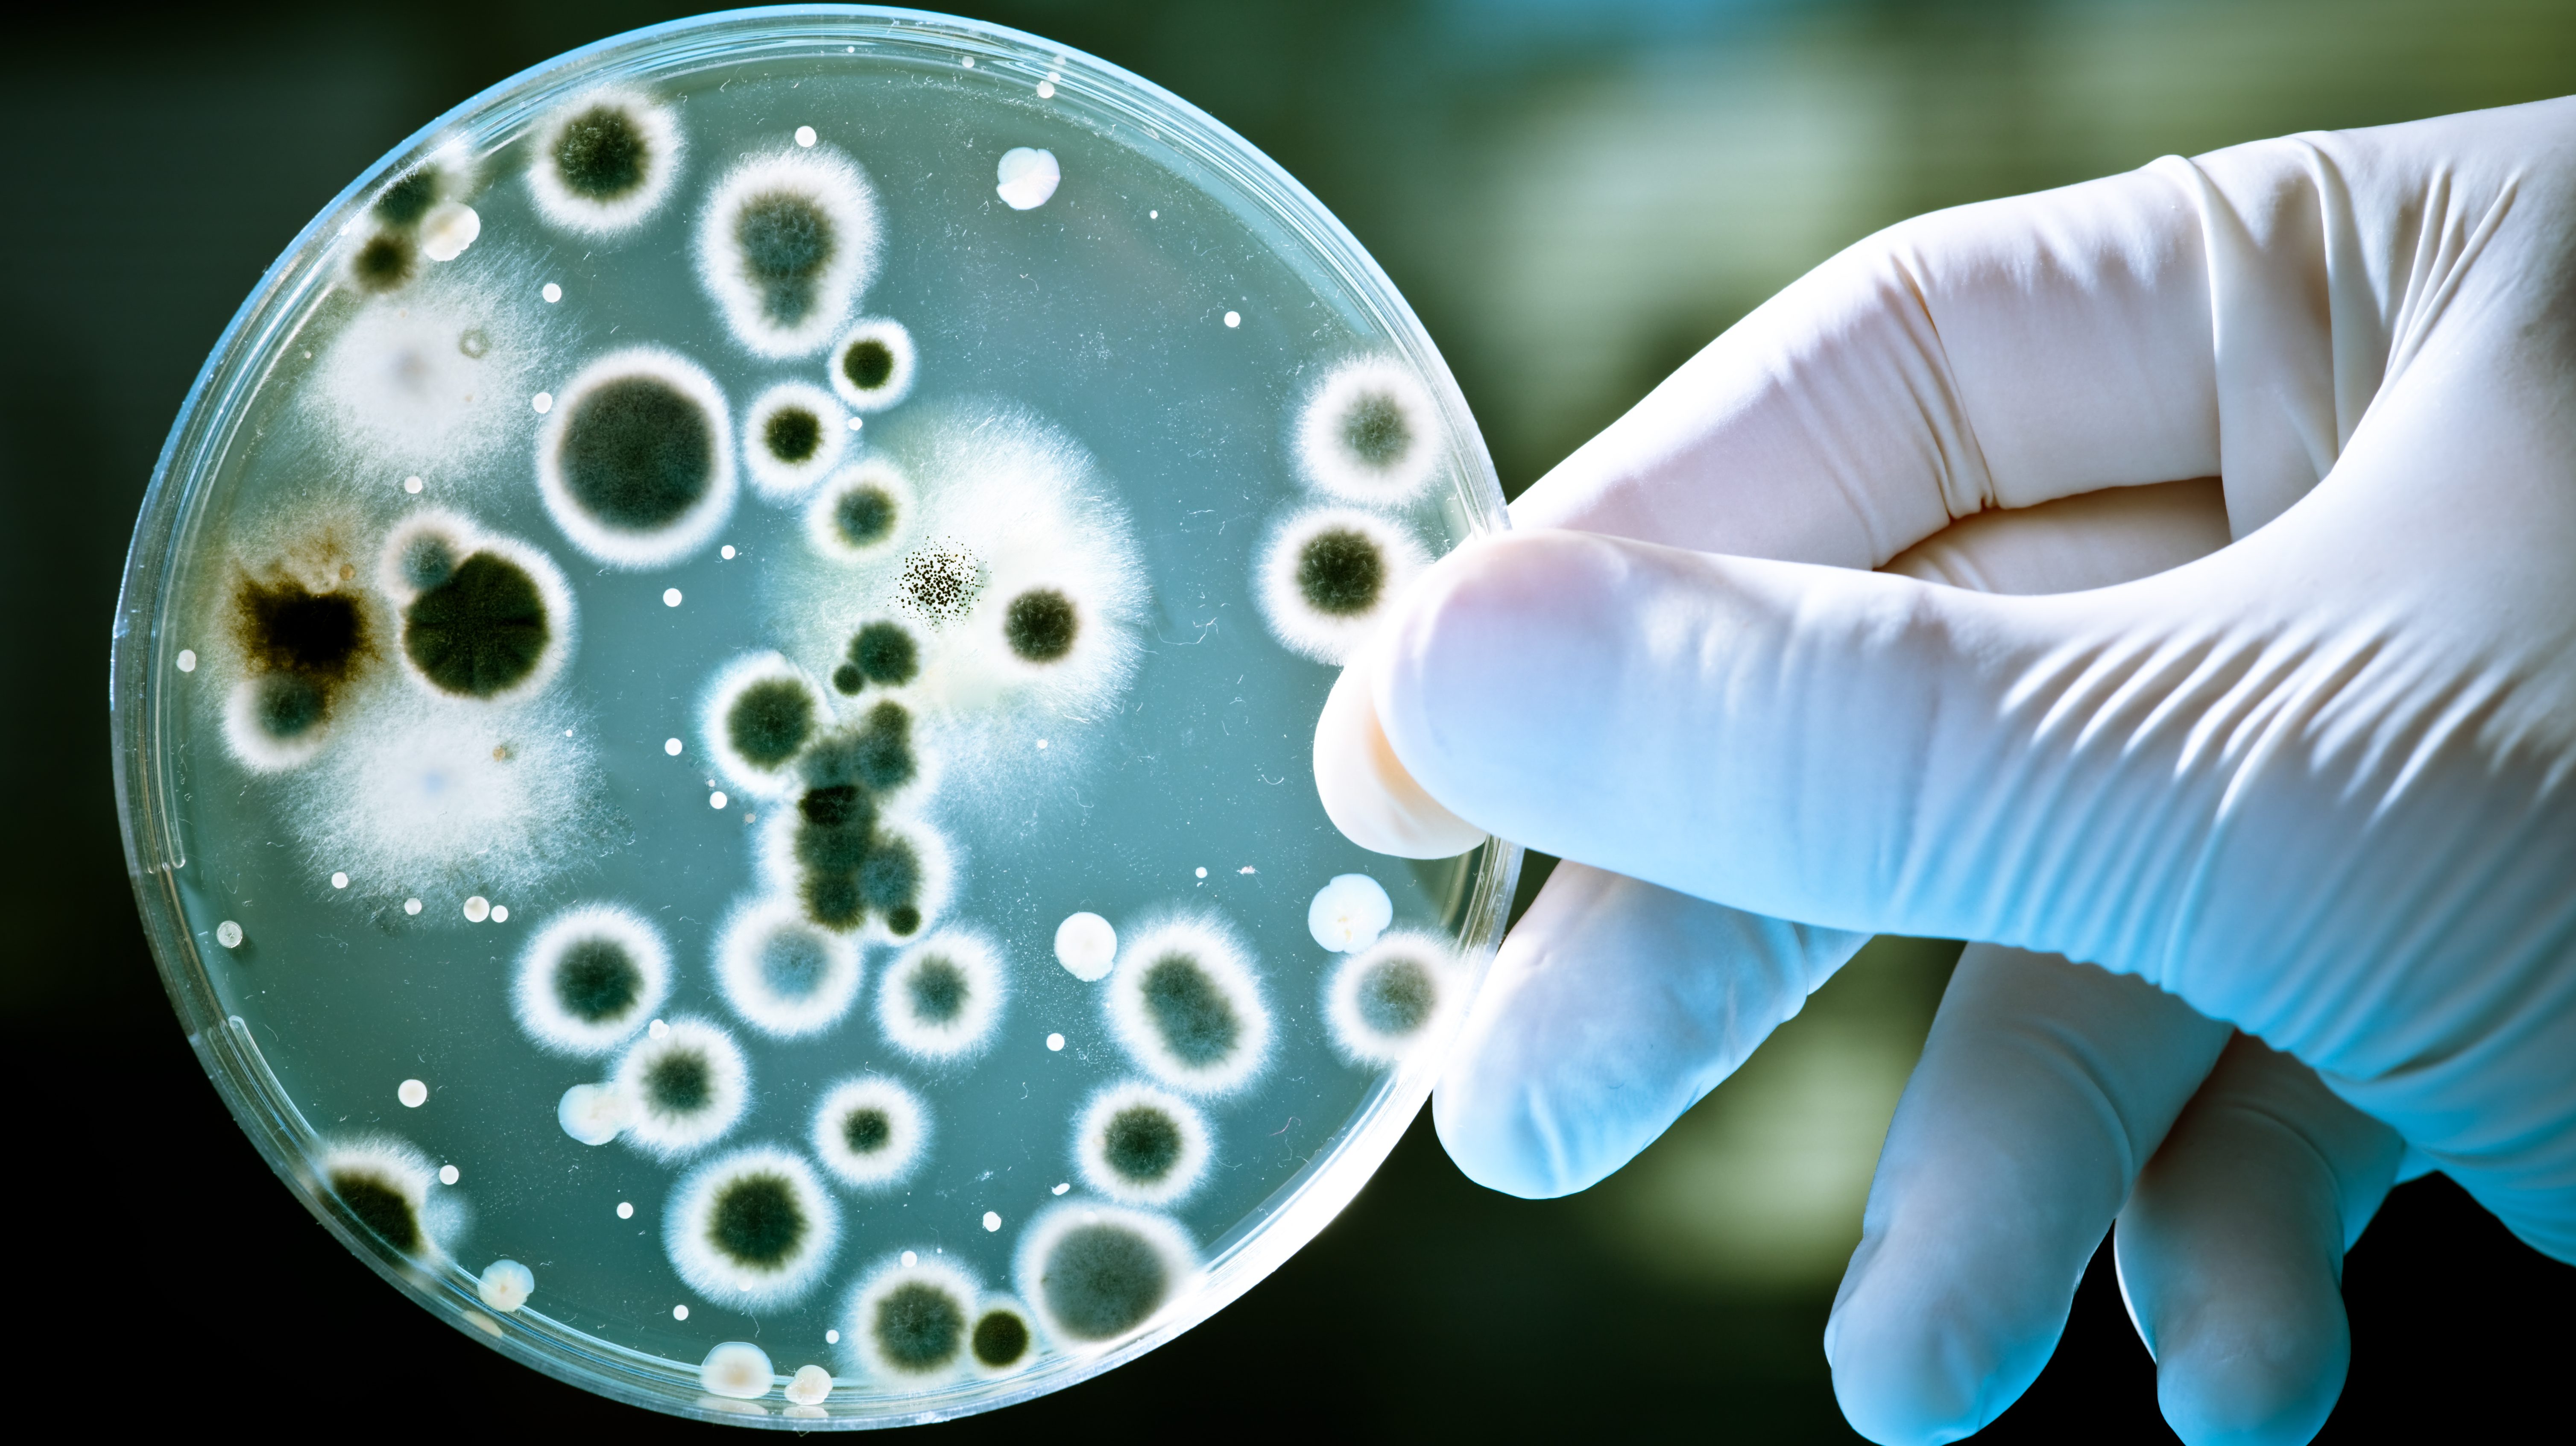
bactéries résistantes

Des chercheurs du MIT et d’Harvard aux États-Unis ont découvert grâce à un algorithme d’intelligence artificielle une nouvelle molécule antibiotique capable de tuer des bactéries résistantes aux antibiotiques traditionnels, une percée majeure longtemps attendue.
Les antibiotiques actuellement utilisés sont déjà anciens, et le processus traditionnel pour en découvrir de nouveaux est coûteux et lourd.
L’intelligence artificielle (IA) permet de rechercher, «in silico» c’est-à-dire par modélisation informatique, quelles molécules chimiques seraient à même de s’attaquer à certaines bactéries, en faisant examiner des bibliothèques de composés chimiques par l’IA.
«Nous voulions développer une plateforme permettant d’exploiter la puissance de l’intelligence artificielle pour ouvrir une nouvelle ère de découverte de médicaments antibiotiques», explique James Collins, professeur d’ingénierie médicale au MIT, coauteur de cette découverte publiée jeudi dans la revue Cell. «Notre approche a révélé cette molécule incroyable qui est sans doute l’antibiotique le plus puissant jamais découvert».
L’IA permet d’élargir le champ des candidats-médicaments à des molécules que les chercheurs ne soupçonnaient pas. L’idée n’est pas nouvelle (des décennies), mais jusqu’à présent, les méthodes n’étaient pas assez raffinées pour vraiment trouver des molécules efficaces.
Les chercheurs ont entraîné leur modèle à partir de la bactérie Escherichia coli, puis ont recherché parmi une bibliothèque de 6000 composés chimiques lesquels avaient les caractéristiques recherchées. L’algorithme a trouvé un composé à la structure différente des antibiotiques existants, et prédit qu’il serait efficace contre de nombreuses bactéries.
Ils ont baptisé la molécule «halicin», en hommage à l’ordinateur HAL du film 2001, l’Odyssée de l’espace, puis l’ont testée en laboratoire contre des dizaines de souches bactériennes prélevées sur des patients et cultivées in vitro.
L’halicine a réussi à tuer de nombreuses bactéries résistantes aux antibiotiques existants, notamment Clostridium difficile, Acinetobacter baumannii, et Mycobacterium tuberculosis. Seule la bactérie Pseudomonas aeruginosa lui a résisté.
Enfin, la nouvelle molécule a été testée sur des souris infectées par A. baumannii, une bactérie qui a infecté de nombreux soldats américains en Irak et en Afghanistan, et qui résiste à tous les antibiotiques existants. Les souris furent guéries en 24 heures.
Les auteurs espèrent que leur modèle permettra de renforcer tout l’arsenal antibiotique, alors que la résistance aux antibiotiques est un sujet d’inquiétude mondiale des autorités sanitaires. L’Organisation de Coopération et de Développement Économiques (OCDE) a estimé récemment que les bactéries résistantes pourraient tuer 2,4 millions de personnes en Europe, en Amérique du Nord et en Australie d’ici 2050.